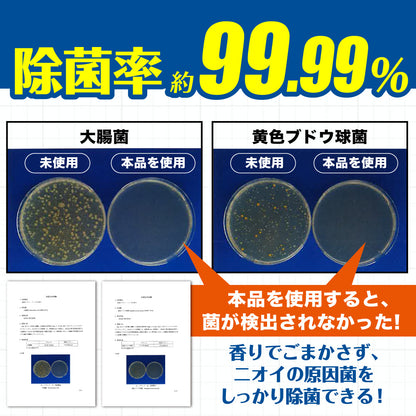
★つりケア魚臭撃退 消臭スプレー つめかえ用 280ml

1
/
の
20
★つりケア魚臭撃退 消臭スプレー つめかえ用 280ml
★つりケア魚臭撃退 消臭スプレー つめかえ用 280ml
通常価格
¥550
通常価格
セール価格
¥550
単価
/
あたり
税込。
配送料はチェックアウト時に計算されます。
低在庫
2 reviews
受取状況を読み込めませんでした
つめかえ用(280ml)
香りでごまかさず、しっかりと「魚臭」を取り除いてヒノキの良い香りに。
・車内空間・ウェア・シューズなどから臭う魚臭にシュッとスプレーして消臭。
・柿渋エキス配合で魚臭に効く。魚臭に特化した処方だから、釣り人におすすめ!
・化学的消臭法で悪臭成分を撃退。消臭・除菌 (※すべての菌を除菌するわけではありません。)
・ヒノキの香りでスッキリさわやか。
<使い方>
【1】対象物から20〜30cm離して、全体が軽く湿る程度にスプレー
【2】風通しのよい日陰でよく乾かしてください。
車内空間に使用する場合は4ドアセダン車で4〜5回を目安にスプレーしてください。
平日12時までのご注文で メール便: 注文から最短1〜4日で倉庫発送 宅配便: 注文から最短当日発送
詳細を表示する




















匿
匿名 詰め替え待ってました!
キャップ付きなので、足したい分だけ足せて便利です!
け
けんじ 釣行後の魚のニオイ対策として重宝しています。車内やウェア、グローブに使ってもベタつかず、香りでごまかす感じではなくニオイが落ちてすっきりします。ヒノキ系の香りも強すぎず上品で、家族からの反応も良いです。詰め替えがあるので継続しやすく、釣り道具と一緒に常備しています。